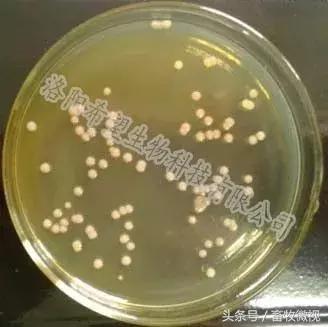
凝结芽孢杆菌作用机理及功能特点

关于凝结芽孢杆菌的记录最早出现于1915年,1932年俄国科学家L.M.Horowitz-Wlassowa和 N.W.Nowotelnow在其发表的科学文献中首次使用“孢子乳杆菌”(Lactobacillus sporogenes)来描述凝结芽孢杆菌。1980年,学术界统一命名了凝结芽孢杆菌,确定其模式菌株为ATCC(美国典型培养物保藏中心)7050。该菌株的特点是生长旺盛,芽孢产率高,乳酸产率高,已通过我国药品生物制品检定所检定并批准使用,并已列入我国农业部允许添加的微生物菌种目录。
凝结芽孢杆菌(Bacillus coagulans),又称乳酸芽孢杆菌,分类学上属于芽孢杆菌属,细胞呈杆状,菌体大小(0.7~0.8)×(3~5)μm,单个、成对存在,很少成直链排列,革兰氏阳性菌,端生芽孢,无鞭毛。兼性厌氧,15~45℃均可生长,分解糖类生成L-乳酸,为同型乳酸发酵菌。最适pH范围6.6-7.0。凝结芽孢杆菌可以在室温保存,有效期可达24个月。
凝结芽孢杆菌作用机理及功能特点
(一) 凝结芽孢杆菌作用形式
凝结芽孢杆菌不是动物肠道固有的微生物,当以芽孢的形式进入消化系统后,经过胃的蠕动以及胃酸的刺激,芽孢开始吸水、膨胀,启动萌发过程。当进入萌发阶段的芽孢到达十二指肠后,芽孢体便彻底转变为营养细胞,营养细胞进入小肠后开始生长繁殖,大约每30min 繁殖一代,从而在肠道内迅速增加数量。伴随凝结芽孢杆菌在肠道中的不断繁殖,大量的代谢产物如:L(+)-乳酸、凝固素、lactosporin、α-淀粉酶、脂肪酶及蛋白酶等生成,从而有效地发挥其益生功效。作为肠道内的“移民”,凝结芽孢杆菌只能在肠道内做短暂的停留,一次性口服凝结芽孢杆菌后,经过大约 4~7d时间肠道内的凝结芽孢杆菌便会通过排便而消失殆尽。所以应定期和持续使用凝结芽孢杆菌菌剂,以保证在肠道中充分发挥其益生作用。
(二) 作用机理
1. 凝结芽孢杆菌为兼性厌氧菌,当其进入肠道后会消耗游离氧而进行肠道繁殖,有利于厌氧微生物乳酸菌和双歧杆菌的生长,从而调节肠道内微生物菌群的平衡。
2. 凝结芽孢杆菌在肠道内繁殖会分泌淀粉酶和蛋白酶,促进营养物质的消化和吸收;其产生的维生素、氨基酸、短链脂肪酸等物质能增加小肠蠕动速度,改善肠道消化功能。
3. 凝结芽孢杆菌产生的乳酸、抗菌凝固素及多种酶能抑制有害菌的繁殖,有通便、止泻作用。
4. 无任何毒副作用,使用安全,另外凝结芽孢杆菌在代谢过程中能产生抑菌物-凝结素,因此对胃肠道炎症有一定治疗作用。
(三) 产品功效
1. 有效抑制有害菌的生长,改良肠道微生态环境,促进肠道发育,增强肠道功能
2. 提高饲料品质,促进机体消化代谢,降低料重比。
3. 提高机体免疫能力,有效改善断奶仔猪由于应激、过敏反应引起的菌群失调性腹泄。
4. 无任何毒副作用,使用安全,并可降低环境中的氨气、硫化氢等有害气体,改善养殖环境。
产品简介:希望复合凝结芽孢杆菌
(一) 主要成分
凝结芽孢杆菌活菌体、固体发酵代谢产物、促营养吸收因子等。
(二) 产品特点
希望生物凝结芽孢杆菌芽孢率高,杂菌率低,菌株活力强,耐高温,耐酸碱,繁殖快,适应强。
(三) 技术指标
|
凝结芽孢杆菌有效活菌数(亿/g) |
50—200亿/克 |
|
杂菌率 |
≤0.005% |
|
产品细度 |
≥60目 |
|
芽孢率 |
≥98% |
|
产品含水量 |
≤10% |
(四) 适用范围
本品可以用在猪、禽类、反刍动物以及鱼虾等水产动物饲料中。
(五) 用法用量
在混合饲料中充分拌匀,长期使用建议每吨饲料添加50-500g,治疗肠道疾病建议每吨饲料添加1-2kg。
(六) 注意事项
不可与杀菌剂同时使用(可在杀菌剂使用24小时以后添加)。
产品优势
为什么国外的微生态制剂很少标注活菌含量?而其使用效果要优于国内同类产品?根据最新的研究结果,在动物肠道内起促进营养吸收、分解原料大分子为更易于吸收的小分子(例如小肽)、抑制拮抗病原菌等作用的并不是微生物菌体本身,而是这些益生菌在生命活动过程中分泌释放的具有生物活性的大分子物质,例如酶类、催化蛋白、抑菌肽等。国内的微生态制剂,多数是以液体发酵+喷雾干燥的工艺来生产,这种发酵工艺的一个不足之处是虽然可是获得很高的菌数,例如可以做到1000亿/g甚至3000亿/g,但是由于菌体的发酵生长过程处于接近理想的状态,相当于温室里长大的花朵,没有经历风雨的洗礼,也很少分泌酶、抑菌肽等物质,即使有少量活性分子,在后期喷雾干燥的过程中,由于经历了100度以上的高温,能存留下来的也很少,所以这类产品虽然菌数很高,但使用效果却差强人意。
作为中国最专业的凝结芽孢杆菌生产基地,希望生物的凝结芽孢杆菌发酵采用液体菌种+固体发酵+低温干燥的工艺,液体发酵的菌体作为种子接种到固体发酵设备中,在固体发酵阶段,由于固体发酵基质的异质性,菌体在生活繁殖过程中,不得不尽量多的分泌酶类、有机酸类、抑菌肽等物质,来获得最大的生长速度和数量,虽然最后得到的产物里含有大量对动物肠道有益的生物活性分子。在后期我们采用低温干燥工艺,干燥温度在50℃左右,最大限度的保留前期获得的有益物质和菌体,所以在使用效果上接近国外同类产品!
产品检测鉴定
市场上的凝结芽孢杆菌产品种类较多,良莠不齐,可对使用的凝结芽孢杆菌产品按以下方法检测,实验地点希望生物科研中心。必要时可送具资质的第三方检测机构鉴定。
(一) 实验室培养
采集样品,经活化->菌液->平板分离->挑取单菌落纯化等制备纯菌种按以下鉴定方法进行鉴定。
(二) 菌株的筛选鉴定
形态学特征:凝结芽孢杆菌在LB、MRS、土豆固体培养基上均可良好生长,48h形成直径2~3mm大小的圆形菌落,白色而有光泽,表面湿润、平坦,边缘整齐,如图1;1600x油镜观察,菌体形态为杆状,单个、成对或链状排列,芽胞端生,如图2。
图1

图2
1. 生理生化特征鉴定
革兰氏染色 阳性(在生长静止期可能为阴性)
37℃生长 +
厌氧生长 +
氧化酶过氧化氢酶 +
葡萄糖氧化发酵 +
甲基红 +
V-P测定 +
淀粉水解 —
吲哚产生 —
明胶液化 —
注:“+”表示阳性,“-”表示阴性。
(一) 活菌计数
采用孢子浓度法计算每克凝结芽孢杆菌样品中的活芽孢数量,以cfu/g 表示。
1、试剂与材料
除非另有说明,在分析中仅使用确认为分析纯的试剂和蒸馏水或去离子水或相当纯度的水。
LB培养基,市售或按下面配方配制。
胰蛋白胨(Tryptone) 10g/L,酵母提取物(Yeast extract) 5g/L,氯化钠(NaCl) 10g/L,琼脂粉 15-20g/L。
1.1 试剂
灭菌生理盐水(m/m),0.85%。
吐温 80 溶液(v/v),10%:准确移取 10mL吐温 80 于 100mL容量瓶中,用蒸馏水定容混匀后转至合适容器中灭菌备用。
稀释液:在无菌生理盐水中按照 1%的比例加入吐温 80 溶液,配制成稀释液,混合均匀待用。
1.2 仪器设备(希望生物科研中心)
除常用微生物实验室设备外,其他设备和玻璃器皿如下:
电子天平,精确到 1mg。
隔水式电热恒温培养箱,可控温至 37℃±1℃。
压力蒸气灭菌器,可控温至 121℃±2℃。
pH 计,精度为 0.1 个单位。
超净工作台。
移液器,量程分别为 0.2mL、1mL、5mL及配套吸头或者用标记容量为 10mL和 1mL的刻度吸管
试管和配套硅胶塞,18×180mm。
塑料离心管,50mL。
玻璃涂布棒。
玻璃珠,直径约为 1~3mm,数量若干。
2、分析步骤
每个样品需按以下步骤重复检测 2-3 次。
2.1 提取芽孢杆菌
1) 称取样品 1g±0.5mg,置于已灭菌的 50ml 塑料离心管(内含玻璃珠 20-30 个)中。
2) 加入19ml稀释液,室温摇震一定时间,制成 1:20 的初始菌悬液。样品的稀释(必须在超净工作台中进行)。
3) 将提取好的提取管置于 80℃±1℃水浴锅中水浴 10min,取出立刻冷却至室温。
4) 用移液器或无菌吸管准确移取菌悬液1mL,加入到盛有9mL稀释液的无菌试管中混匀,即得1:10。以此类推。
注:每递增稀释一次必须更换无菌吸管或吸头;每次稀释后需混合均匀,再进行下一步操作。并在试管上标记样品号和稀释倍数的字样。
2.2 样品的平板培养
1) 根据样品含量和检测需要选择 2-3 个适宜稀释度,用移液器或无菌吸管分别吸取不同稀释浓度菌悬液 0.1mL,涂布样液接种于培养基表面。
2) 每个稀释度做三个重复。
3) 将涂布好的平皿盖好,标上样品号和稀释度。倒置于 37℃±1℃的恒温培养箱内培养 16-20h。
2.3 菌落计数方法
1) 培养结束后,选取适宜稀释度的平板的菌落数平均值乘以相应稀释倍数计算出每g(mL)样品中平板菌落数,取菌落数在 30-300 个之间的平板计数。
2) 若片状菌落不到平板的一半,而其余一半中菌落分布又很均匀,即可计算半个平板后乘以 2 以代表全皿菌落数。
3) 当只有一个稀释度时,其平均菌落数均在 30-300 之间,则以该平均菌落乘以其稀释倍数。
4) 若三个稀释度的平均菌落数均大于 300,则应按稀释度最高的平均菌落数乘以稀释倍数。
5) 若三个稀释度的平均菌落数均不在 30-300 之间,则以最接近 30 或 300 的平皿计算报告菌数。
6) 当各稀释度的平均菌落数均小于 30,以最低稀释度的平均菌落数乘以稀释倍数的值报告菌数。
2.4 结果计算
根据菌落数特征判定,分别数出平板中芽孢杆菌菌数及杂菌数,计算出同一稀释度三个平皿上菌落平均数(B),报告每g(ml)样品中平板菌落数。
有效活菌总数按式(1)计算;
N=(A/B)×n …………………………………………………………(1)
式中:
A——有效平板上的平均菌落数,cfu/g(ml);
B——接种量(ml);
n——稀释倍数。
杂菌率D,按(2)计算;
D=E/(E+N)×100% ……………………………………………………(2)
式中:
D——杂菌率,100%;
E——杂菌数;
N——上式(1)计算结果。
检测市场上的凝结芽孢杆菌
凝结芽孢杆菌如此功效,且无副作用,对于市场上的各种产品我们要如何更加简单快捷地鉴别凝结芽孢杆菌的真伪,希望生物科研人员分享如何辨别凝结芽孢杆菌?
众所周知,凝结芽孢杆菌是一种可以产乳酸的芽孢杆菌,而枯草芽孢杆菌、地衣芽孢杆菌、蜡样芽孢杆菌等芽孢杆菌是不产酸的,而丁酸梭菌虽然产酸,但却是严格厌氧细菌而且产的是丁酸,在有氧气存在的条件下不能生长,因此可以通过好氧培养来区分凝结芽孢杆菌和丁酸梭菌。
(一) 产酸性能的检测
方法如下:
1、 简易麸皮+葡萄糖发酵实验(地点:希望生物科研中心)
A、20g 麸皮+2g 葡萄糖+2g 微生态产品+120ml 沸水(煮开);冷却到室温条件下测定初始 pH,并记录;在温度 35-40℃(一方面给细菌提供合适的生长温度,另一方面动物体的体温也是在37-40℃范围)条件下放置24-30小时后再测定pH。
B、20g 麸皮(高压蒸汽灭菌)+2g 葡萄糖+2g 微生态产品+120ml 沸水(煮开):
冷却到室温条件下测定初始 pH,并记录;在温度 35-40℃条件下放置 24-30 h后再测定 pH。
具体操作步骤如下:
1.1 找一只干净的玻璃杯,将 20g 麸皮倒进玻璃杯中,加入 2g 葡萄糖和 2g微生态产品,搅拌均匀;
1.2 取自来水煮沸,在玻璃杯中倒入 120ml 的煮沸的开水(相当于一次性塑料杯容量的开水),搅拌均匀;
1.3 冷却到室温时,用笔试酸度计(结果较为准确,以免难以区别颜色)检测 pH 值,并记录初始 pH。
1.4 然后放于温度35-40℃(温度一定掌控好)条件下放置 24-30 小时后再测定pH,并记录结果。
2、 碳酸钙平板实验
2.1 碳酸钙平板的制作:
1) 碳酸钙培养基:蛋白胨 20g,酵母粉 10g、葡萄糖 20g,碳酸钙(分析纯)1g,琼脂粉 15g,蒸馏水1000mL,115℃灭菌 20min;
2) 碳酸钙平板制作:将上述碳酸钙培养基冷却到 55℃时(不烫手),在超净工作台内倒制平板(90mm 平板),每个平板 20ml 培养基,冷却后待用。
2.2 菌种液体培养:
1) 液体培养基:蛋白胨 20g,酵母粉 10g、葡萄糖 20g,115℃灭菌 20min,冷却后待用;
2) 在超净工作台中将微生态产品的菌种接到上述液体培养基中,在 38-40℃恒温摇床中培养 20-24 小时。
2.3 碳酸钙分解实验
在超净工作台中,用接种环挑取培养好的液体培养液点接到碳酸钙平板上,然后至于 38-40℃恒温箱中培养(注意:平板要倒置),24-36 小时后观察平板中碳酸钙水解情况(根据碳酸钙和菌株的特性,培养时间有所差别)。实验结束时用游标卡尺测量水解圈大小即可。如图3所示。

图 3凝结芽孢杆菌在培养基上产生碳酸钙溶解圈
3、结论
3.1 实验1可以验证微生态产品是不是芽孢杆菌,活菌体不能在 80℃条件下存活,能不能产芽孢;
3.2 实验2可以验证微生态产品是否产酸;
3.3 产酸+产芽孢=凝结芽孢杆菌。当然产酸+产芽孢的菌还有一种是丁酸梭菌,但是丁酸梭菌是严格厌氧细菌而且产的是丁酸,在有氧气存在的条件下不能生长,因此可以通过好氧培养来区分凝结芽孢杆菌和丁酸梭菌。
3.4 通过上诉实验一和试验二可以判定是否为凝结芽孢杆菌 (产酸+ 产芽孢)。




本文为*今条头日**原创并首发,不构成指导意见,仅供学习交流。如有其他问题咨询可关注微信号【lixiang939256】---每天8点-22点在线沟通交流。